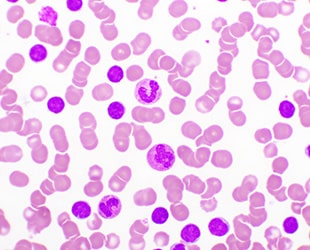

A Combination Treatment May Help Eliminate Daily Therapy for Chronic Lymphocytic Leukemia
De-escalating treatment for patients with chronic cancers can be beneficial for overall mental health.
Patients with chronic lymphocytic leukemia (CLL) are typically treated with Bruton’s tyrosine kinase inhibitors, or BTKis. Although effective, patients typically have to be on this treatment indefinitely, and long-term use can lead to toxicity. However, researchers have found that a new combination treatment could discontinue daily therapy and potentially improve their quality of life, according to a study published in Clinical Cancer Research, a journal of the American Association for Cancer Research (AACR).

BTKis inhibit the activity of the Bruton tyrosine kinase protein, which plays a crucial role in the development and maturation of B cells, a type of white blood cell. The overproduction of these cells is what leads to CLL. BTKis have been revolutionary for patients with CLL, according to John C. Byrd, MD, senior author of the study, who was chair of the Department of Internal Medicine at the University of Cincinnati College of Medicine.
However, many patients find taking the BTKi ibrutinib to be psychologically burdensome, he explained. “Taking a medicine every day can be a reminder of sickness for patients, so it is very symbolic for patients with blood cancers to be able to go off therapy,” added Dr. Byrd, who is currently director of the UPMC Hillman Cancer Center and associate vice chancellor for cancer affairs at the University of Pittsburgh School of Medicine.
Testing a Combination Treatment for CLL
As a potential solution, Dr. Byrd, Kerry A. Rogers, MD, lead author and associate professor from The Ohio State University, and other investigators looked to ianalumab, an investigational drug that has shown superior activity in combination with BTKi drugs when tested against CLL in preclinical studies. “We tested whether this antibody could eliminate residual disease and even resistant clones, offering patients a chance to come off therapy,” Dr. Byrd explained.
Dr. Byrd and colleagues conducted a phase I, open-label, multicenter trial enrolling 39 patients who did not have complete remission on ibrutinib or had developed resistance mutations. Participants received intravenous ianalumab every two weeks alongside a standard dose of ibrutinib for up to eight cycles. The study evaluated safety, tolerability, and antitumor activity, as well as whether the combination could deepen responses enough to discontinue BTKi therapy.
Two Treatments Led to Less Therapy and Toxicity
The combination therapy had no dose-limiting toxicities, according to Dr. Byrd. Grade 3 or greater adverse events occurred in 41% of patients, primarily low levels of neutrophils, which are a type of white blood cells that help ward off infections and are an important part of the body’s immune system. Overall response was nearly 60%, and 43.6% had undetectable measurable residual disease—the small amounts of cancer cells that can remain after treatment.
Dr. Byrd noted that 17 patients were able to stop ibrutinib and remain off therapy for 12 to 24 months. Biomarker analyses indicated that ianalumab enhanced NK and T-cell activation, supporting its proposed mechanism of action.
Measurable residual disease was undetectable in 13 patients in both blood and bone marrow, and in four patients solely in bone marrow, which Bryd noted as deep responses. “Patients who experience deep responses can stop daily medication, a powerful shift that removes the constant reminder of cancer,” said Dr. Byrd.
The findings have important implications for patients living with CLL, Dr. Bryd added. Data showed that this approach could help patients avoid the cumulative toxicity associated with lifelong BTKi therapy. The infection rates in the patients in this trial were lower than those historically reported with single-agent BTKi therapy, suggesting that adding ianalumab did not increase infection risk. “These results point to potentially using fixed-duration combination therapy to achieve remission and reduce the burden of continuous treatment,” Dr. Byrd said.
The limitation of this study is the small sample size and lack of long-term follow-up. “A larger trial is needed to confirm whether this approach can become a standard strategy for reducing BTKi treatment duration,” said Dr. Byrd.